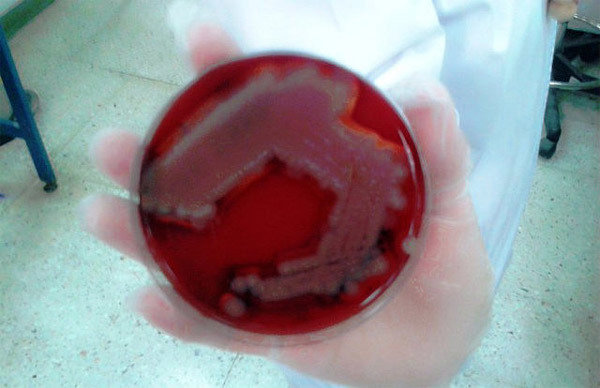
{keywords}

Một căn bệnh bí hiểm giết chết 18 người ở tây nam Nigeria chỉ trong vòng
vài giờ khiến các nhà chức trách nước này đang cuống cuồng tìm hiểu nguyên nhân.
TIN BÀI KHÁC:
Giới chức y tế Nigeria cho biết, ổ dịch bùng phát ở bang Ondo của Nigeria từ ngày 13/4.
TIN BÀI KHÁC:
Giới chức y tế Nigeria cho biết, ổ dịch bùng phát ở bang Ondo của Nigeria từ ngày 13/4.
Bác sĩ Dayo Adeyanju, cao ủy về sức khỏe của bang Ondo, xác nhận đã có 18 người chết và 5 người đang được điều trị. Đối tượng bị bệnh ở độ tuổi từ 25 đến 60 và bệnh lạ này không lây nhiễm.
![]() |
| Mô tả |
Ông Adeyanju cho hay, các triệu chứng gồm đau đầu, mờ mắt, mất thị lực và bất tỉnh. Một số người nghi ngờ có thể là do một loại rượu chưng cất ở địa phương.
![]() |
|
|
![]() |
|
|
Các nhà điều tra đã gửi các mẫu máu, mẫu nước tiểu và tủy tới một trường đại học ở thành phố Lagos để xét nghiệm.
![]() |
![]() |
|
|
WHO cho biết, các thử nghiệm loại trừ nguyên nhân bệnh do virus hoặc vi khuẩn. Bệnh cũng không liên quan gì đến Ebola, đại dịch đã cướp mạng sống của hàng hàng nghìn người ở các nước láng giềng của Nigeria mới đây.
![]() |
|
|
Thanh Hảo